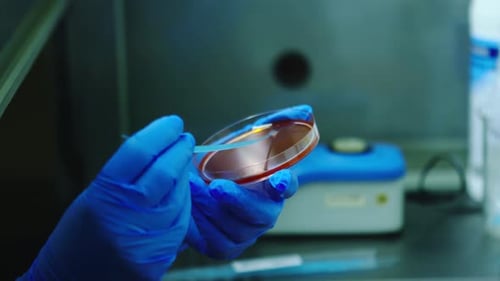
Laboratory Sample Streaking in Petri Dish

Rows of Medical Vials in a Bright Laboratory
By LENSLOGICOne great value subscription from $16.50/month
- Unlimited downloads of 27+ million creative assets
- AI Tools: video, image and more
- Lifetime commercial license
- Easy cancellation
Already have an account? Sign in
Attributes
- Length
- 0:13
- Resolution
- 3840 x 2160
- File Size
- 293 MB
- Frame Rate
- 29.97 fps
- Alpha Channel
- No
- Looped
- No
- Video Encoding
- Photo JPEG
- Orientation
- Horizontal
- Commercial License
- Further Information
Description
Rows of clear glass vials and test tubes with white or blue caps sitting in trays in a laboratory. The trays are on a white surface and in the background is more lab equipment. The lighting is bright. This footage could be used for videos about medical research, pharmaceutical science, laboratory work, vaccines, and quality control.
All
Music
Sound Effects